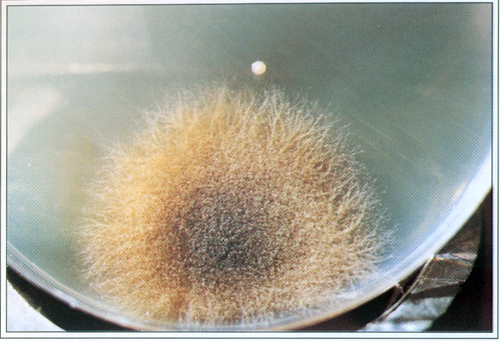
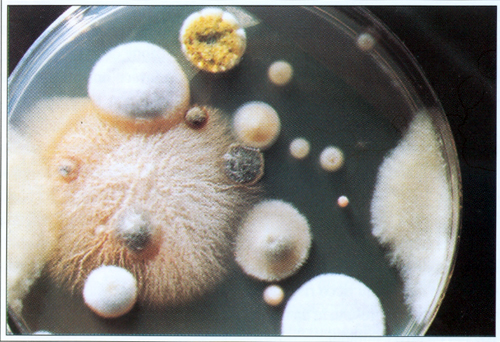
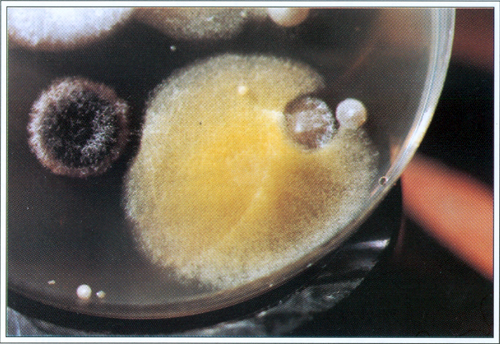
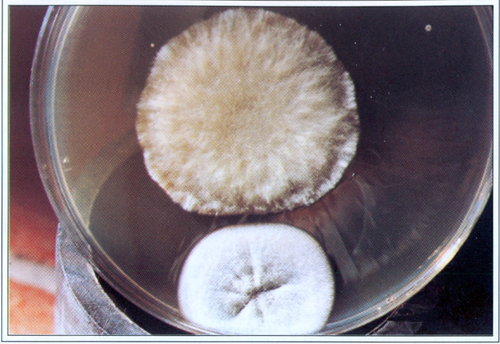
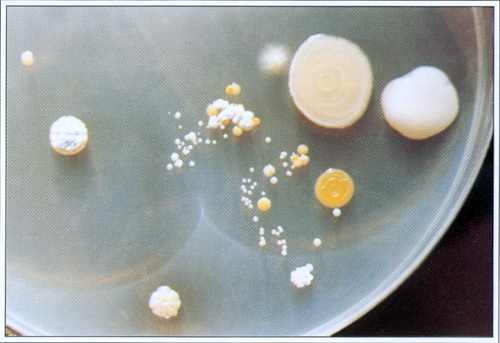
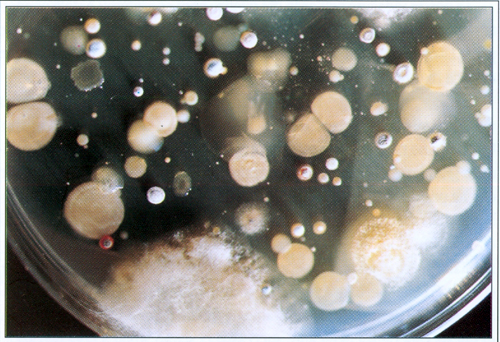
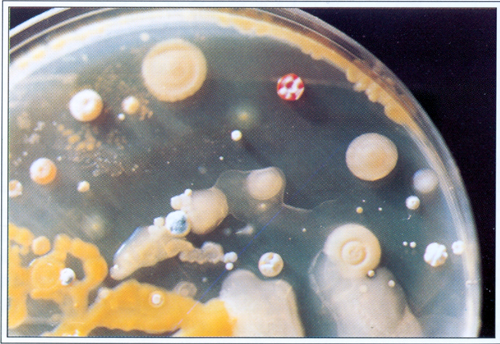

|
3
1
2
3
4 6 7 8
9
4
(p.5 di 9)
|
|
3. IL SUOLO
|
 |
|
TABELLA 8. Riepilogo risultati delle analisi chimiche
effettuate nel febbraio 1996.
|
|
|
35. Miceti sviluppati su terreni
di coltura Patato Dextrose Agar.
|
|
|
36. Miceti sviluppati su
terreni di coltura Patato
Dextrose Agar.
|
|
|
37. Miceti sviluppati su
terreni di coltura Potato Dextrose Agar.
|
 |
38. Miceti sviluppati su terreni
di coltura Patato Dextrose Agar
|
|
|
39. Miceti sviluppati su
terreni di coltura Patato
Dextrose Agar.
|
|
|
40. Batteri ed attinomiceti
sviluppati su terreno di coltura Malt Agar.
|
|
|
41. Batteri ed attinomiceti
sviluppati su terreno di coltura Malt Agar.
|
|
|
42. Batteri ed attinomiceti
sviluppati su terreno di coltura Malt Agar.
|
|
4. ASPETTI VEGETAZIONALI
|
 |
|
TAVOLA 25. Carta delle
vegetazioni.
|
 |
|
TAVOLA 26. Carta della assolazione.
|
 |
|
43. Quercus pubescens.
|
 |
|
44. Myrtus communis.
|
 |
|
45. Smilax aspera.
|
 |
|
46.
Lonicera
caprifolium
|
4. ASPETTI VEGETAZIONALI
(...continua...)
|
|
3
1
2
3
4 6 7 8
9
4
(p.5 di 9)
|

|
|
Torna
alle Gallerie foto da libri |